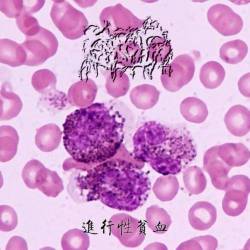
Progressive Anemia

Gatunek
Black Metal
Status
Aktywny
Data założenia
2008
PaństwoChina
Miasto
Qiqihar
Popularność
Fani
0